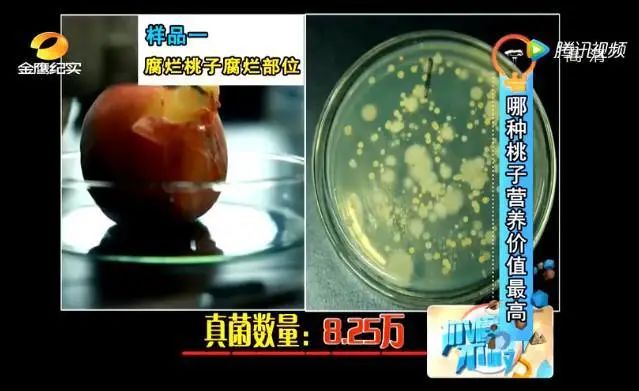

烂了一部分的水果,扔掉还是吃掉?
年轻人普遍观点是:烂了就扔,指不定里面坏成什么样。
继承了勤俭节约美德的爸妈和长辈们,总会发出灵魂拷问:只是烂了一部分,怎么就不能吃了呢?
想法经常碰撞的结果往往是,年轻人碰一鼻子灰,爸妈和长辈们继续吃烂水果……



所以回到关键问题上:
烂了一部分的水果,到底该扔掉还是吃掉?

水果削掉坏的部分,还能不能吃?
烂了一半的水果,内部发生了什么?
削掉一半吃下去,会有什么影响?
如何正确处理?都是烂了就扔吗?
发霉的水果不论大小
都可能含有多种真菌毒素
我们都知道水果容易霉烂,但原因可能大家不一定清楚。
其实任何食物表面都围绕着一群饥渴的微生物,常见的就是霉菌,水果的发霉腐烂,主要就由它而起。
大部分水果都是汁多糖多营养多,非常适合霉菌拿来养育下一代。只要有机会,霉菌就能立刻入侵果肉并大量繁殖,造成腐烂。

不同形式不同程度花式腐烂的橘子
图片来源:参考文献 6
霉菌其实是一个大家族,一般的霉菌,吃下去也不会把你怎么样,但有不少霉菌在适合的条件下,会产生非常危险的毒素。
水果中常见且值得担心的真菌毒素有 2 种:
展青霉产生的展青霉素(Patulin,PAT)
赭曲霉毒素 A(Ochratoxin A,OTA)
这 2 种毒素明确有害健康,国际癌症研究机构(IARC)分别将 PAT、OTA 列为 3 类、2B 类致癌物。
不过这两种毒素属于可能致癌物,致癌的危害性不是太高。像 2B 类致癌物,是可能性较低的致癌物质,3 类致癌物,是尚不能分类的致癌物质,人群研究证据不足,暂时不用太担心。
可能有的人会问了,只要是烂掉的水果,都有这些毒素吗?
还真是,因为这两种毒素污染的水果都挺常见的。
展青霉素(PAT)可以破坏肠道、损伤肾功能,又能污染各种新鲜水果以及果汁,是一个普遍存在的危险分子。
赭曲霉毒素 A(OTA)具有肝肾毒性,能污染一小部分水果,比如葡萄及葡萄制品等(葡萄干、葡萄汁、葡萄酒),此外无花果干、杏干等水果干发生腐坏的话,也可能有被 OTA 污染。
除前面讲到的两种真菌毒素之外,还有少数更厉害的。
比如可能存在于腐坏甘蔗中的节菱孢霉菌毒素,不仅是明确的致癌物,孕妇如果不小心吃了,可能导致胎儿畸形。
又比如是葡萄干、无花果干等水果干发生腐败的话,可能被更强的 1 类致癌物黄曲霉毒素污染。
切掉坏的部分吃剩下的?
其实是在赌运气
很多生活节俭的长辈,经常会切掉水果腐烂的部分,剩下的继续吃。
其实这样风险不小,具体有两个原因。
① 你几乎不可能精准切掉含有毒素的部分
国标规定,水果及果蔬汁饮料中展青霉素含量不得超过 50 微克 / 千克,葡萄制品中赭曲霉毒素 A 的含量不得超过 2 微克 / 千克。
注意,1 微克 = 1 百万分之一克,这是一个非常非常小的单位。
到底小到什么程度?你可以想象一下,大约是一根头发的四百分之一那么重。
只要如此微小的一点点含量,就会对人体产生危害。
这也就意味着,切掉烂的部分其实是个难度极高的技术活,哪怕毒素没扩散,万一手抖了沾上一丢丢烂的部分,可能就是超标的毒素吃进肚里。
相信没有人会拿身体健康去赌这堪比中彩票的运气吧?
② 看起来完好的果肉,可能也已被霉菌污染
除此之外,还有第二个理由也让我们不推荐你切掉坏的部分吃剩下的——因为有些腐烂可能发生在内部,发生在肉眼无法观察的部分。
比如下图中的苹果,红圈标出的棕褐色部分,已经是内部腐烂。
因为水果大多含水量丰富,可以理解为内部的汁液是流通的,霉菌可能随着汁液在内部蔓延,大量肉眼看不见的果肉,可能早已被霉菌占领。
这种情况在容易变软成熟的水果中更为明显,比如芒果、桃子、苹果等。

红圈内的棕褐色部分,是果肉的内部腐烂
图片来源:Washington State University
可能有人会抱有侥幸心理,我削掉坏的剩下的部分,是不是真菌没你说的那么多?
还真不是这样,因为真菌会在烂水果的果肉内蔓延。
湖南台金鹰纪实频道曾做过一档科普栏目,大家看看就能感受到真菌(霉菌)是一群怎样的流动人口。
节目组找了一个腐烂桃子和一个新鲜桃子,分别取样,检测真菌数量。

检测腐烂部分的桃子,真菌数量 8.25 万。
检测同一个桃子未腐烂部分,真菌数量 5.31 万。

检测新鲜桃子,真菌数量 8 千。

很显然,只要桃子发生腐烂,即便是好的那部分,真菌数量比新鲜桃子提升了很多倍。
其实可以理解为,一旦水果腐烂,就算切掉烂的,剩下的部分仍然是歪瓜裂枣。
水果,烂了就扔掉
少数食物,切掉烂的部分还能吃
我们已经知道,一些常见霉菌在适宜条件下会产生致癌毒素,而只要极少的致癌毒素就对人有害,这也就意味着,致癌物其实是没有安全剂量的。
所以我们建议,只要是发霉腐烂长绿毛的水果,不管贵不贵,扔掉也不心疼。
但肯定有些长辈会问,丢了太可惜,是不是所有食物都要扔掉?
如果实在舍不得扔,美国农业部(USDA)提供一个解决方案,大致原则是:
软质的食物,含水量多霉菌蔓延快,扔掉;
硬质的食物,霉菌一般难以在内部蔓延,可以切掉长霉的部分,剩下的继续吃。
常见的食物及处理方式,都在这张表里了:
食物 | 处理方式 |
午餐肉、培根 | 扔掉 |
干燥腌制的火腿 | 切掉发霉的部分 |
硬奶酪 | 至少切掉发霉处附近 2.5 厘米范围,且不要让刀接触发霉部分,剩下的包上保鲜膜冷藏 |
软奶酪 | 扔掉 |
硬质水果蔬菜 (如胡萝卜、甘蓝、甜椒) | 至少切掉发霉处附近 2.5 厘米范围,且不要让刀接触发霉部分,剩下的包上保鲜膜冷藏 |
软质水果蔬菜 (如桃子、西红柿、黄瓜) | 扔掉 |
面包、馒头等 烘焙食物 | 扔掉 |
豆类、坚果 | 扔掉 |
其实长辈们已经习惯勤俭持家,这完全可以理解,也不是坏事。
但为了省几个水果的小钱,冒着生病致癌的风险,实在是不值得。
尤其是很多长辈没有意识到,在不知不觉中习惯吃坏掉的水果,哪怕切掉烂的部分,并不能阻止烂从口入……


为了家人的安全和健康,一定记得提醒他们!
策划 Bruce
责编 feidi
封面图来源 站酷海洛
参考资料
[1] 吴凤琪,岳振峰,张毅, 等.食品中主要霉菌毒素分析方法的研究进展[J].色谱,2020,38(7):759-767.
[2] 杨雪,高亚男,王加启, 等.亚洲和欧美地区霉菌毒素及其暴露风险分析[J].食品工业科技,2020,41(5):311-318.
[3]聂继云.果品及其制品展青霉素污染的发生、防控与检测[J].中国农业科学,2017,50(18):3591-3607.
[4] Molds On Food: Are They Dangerous?https://www.fsis.usda.gov/wps/portal/fsis/topics/food-safety-education/get-answers/food-safety-fact-sheets/safe-food-handling/molds-on-food-are-they-dangerous_/ct_index
[5] 谢汉忠,黄玉南,李 君,庞荣丽,乔成奎,成昕. 葡萄及其制品中真菌毒素研究进展[J]. 农学学报, 2017, 7(12): 70-75.
[6] S. Saito and C. L. Xiao. Prevalence of Postharvest Diseases of Mandarin Fruit in California. Published Online:2 Nov 2017https://doi.org/10.1094/PHP-08-17-0048-RS
